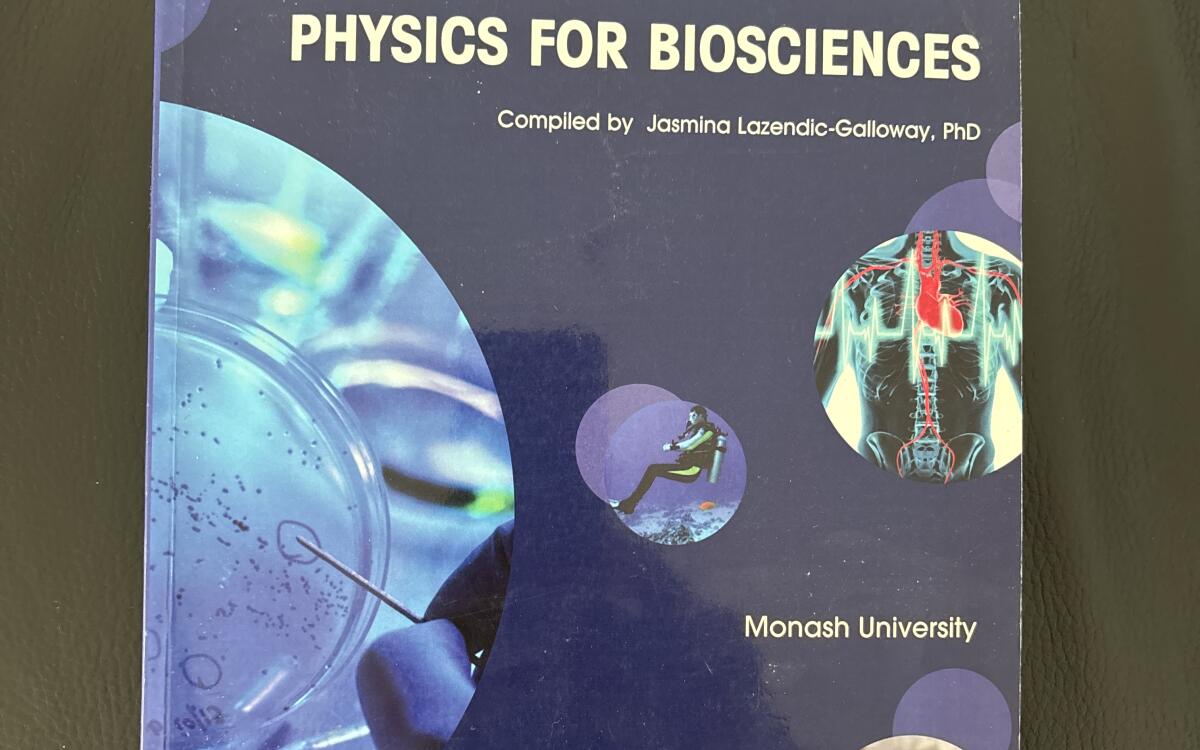

Physics for Biosciences CB
Giancoli
978-1-4860-0928-2
$25
Excellent
In perfect condition except for a few dog eared pages. Selling for my brother who used it in his Biomed course at Monash and is now studying medicine interstate. Could meet at Monash, any other university campus in Melbourne or mutually acceptable location. Delivery by post at additional cost.
19th January, 2026
I'm good to meet on campus
I'm good to meet in the city
I'll post via Australia Post
Contact Noah to buy this textbook (before someone else does!)
You'll need to login to your StudentVIP account in order to contact Noah.
Noah's 8 other textbooks
-
Essential Medical Statistics 2E
Kirkwood, Betty -
Principles of Biochemistry 7e
David L. Nelson -
Biochemistry
Mary K. Campbell, Shawn O. Farrell, Owen M. McDougal -
Chemistry for the Biosciences
Jonathan Crowe, Tony Bradshaw -
Concepts of Genetics, Global Edition
Michael A. Palladino, Charlotte A. Spencer, Michael R. Cummings, William S. Klug - Show more...